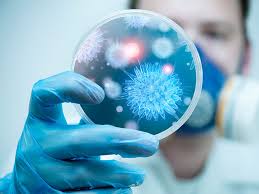

2023-24 IV year I Sem Teachers Grassi massimiliano, Vampa Lisa
- Docente: Silvia Daccò
- Docente: Massimilano Grassi
- Docente: Giampaolo Robert Perna
- Docente: Maria Luisa Vampa

2023-24 IV year I Sem Teachers Vanni Elena, FIoccà Niccolò, Caccamo Stefano
- Docente: Stefano Caccamo
- Docente: Gianluca Cesare
- Docente: Niccolò Fiocca
- Docente: Elena Vanni

2023-24 IV year I Sem Teachers Kon Elizaveta, Castagna Alessandro, Marcacci Maurillo, Bonanzinga Tommaso, Di Matteo Berardo, Loppini Matteo, Massazza Giuseppe, Berardi Daniela
- Docente: Daniela Bernardi
- Docente: Tommaso Bonanzinga
- Docente: Alessandro Castagna
- Docente: Berardo Di Matteo
- Docente: Lorenzo Di Mento
- Docente: Alexander Kirienko
- Docente: Elizaveta Kon
- Docente: Ezio Lanza
- Docente: Mattia Loppini
- Docente: Maurilio Marcacci
- Docente: Giuseppe Massazza
- Docente: Giorgio Pivato
- Docente: Letterio Politi
- Docente: Alessandro Pozzi

2023-24 IV year II Sem Teachers Barbic Franca, Riboli Elio, Stranges Saverio, Vanni Elena
- Docente: Elena Azzolini
- Docente: Franca Barbic
- Docente: Federico Germini
- Docente: Maura Marcucci
- Docente: Holger Schunemann
- Docente: Saverio Stranges
- Docente: Elena Vanni

2023-24 IV year II Sem Teachers Ceribelli Angela, Selmi Carlo Francesco, Costanzo Antonio, Borroni Riccardo
- Docente: Marco Ardigò
- Docente: Michele Bartoletti
- Docente: Riccardo Borroni
- Docente: Linda Bussini
- Docente: ANGELA CERIBELLI
- Docente: Antonio Costanzo
- Docente: Maria De Santis
- Docente: Carlo Selmi
- Docente: Mario Valenti

2023-24 IV year II Sem Teachers Di Tommaso Luca, Terracciano Luigi, Roncalli Massimo, Colombo Piergiuseppe, Uccella Silvia, Renne Lorenzo
- Docente: Arturo Bonometti
- Docente: Piergiuseppe Colombo
- Docente: Luca Di Tommaso
- Docente: Sara Fraticelli
- Docente: Salvatore Lorenzo Renne
- Docente: Massimo Roncalli
- Docente: Luigi Terracciano
- Docente: Silvia Uccella
2023-24 IV year II Sem Teachers Cento Valeria, Morelli Paola, Tordato Federica
- Docente: Michele Bartoletti
- Docente: Davide Bavaro
- Docente: Linda Bussini
- Docente: Valeria Cento
- Docente: Cecilia Garlanda
- Docente: PAOLA MORELLI
- Docente: FEDERICA TORDATO

2023-24 IV year I Sem Teachers Matteoli Michela, Pozzi Davide, Roncalli Massimo, Terracciano Luigi, Di Tommaso Luca, Uccella Silvia, Repici Alessandro, Armuzzi Alessandro, Aghemo Alessio, Hassan Cesare, Maselli Roberta, Carrara Silvia, Lania Andrea, Mazziotti Gherardo, Castoro Carlo, Spinelli antonino, Torzilli Guido, Viganò Luca, Zerbi Alessandro, Sollini Marta
- Docente: Alessio Aghemo
- Docente: Alessandro Armuzzi
- Docente: Maria Francesca Birtolo
- Docente: Ferdinando Cananzi
- Docente: Luca Alessandro Cappellini
- Docente: Giovanni Luigi Capretti
- Docente: Silvia Carrara
- Docente: Michele Carvello
- Docente: Carlo Castoro
- Docente: Luca Di Tommaso
- Docente: Laura Evangelista
- Docente: Marco Francone
- Docente: Cesare Hassan
- Docente: Andrea Lania
- Docente: Roberta Maselli
- Docente: Michela Matteoli
- Docente: Gherardo Mazziotti
- Docente: Marco Mirani
- Docente: Gennaro Nappo
- Docente: Dario Poretti
- Docente: Davide Pozzi
- Docente: Fabio Procopio
- Docente: Nicola Pugliese
- Docente: Salvatore Lorenzo Renne
- Docente: Alessandro Repici
- Docente: Massimo Roncalli
- Docente: Roberta Elisa Rossi
- Docente: Martina Sollini
- Docente: Antonino Spinelli
- Docente: Luigi Terracciano
- Docente: Guido Torzilli
- Docente: Silvia Uccella
- Docente: Luca Viganò
- Docente: Alessandro Zerbi